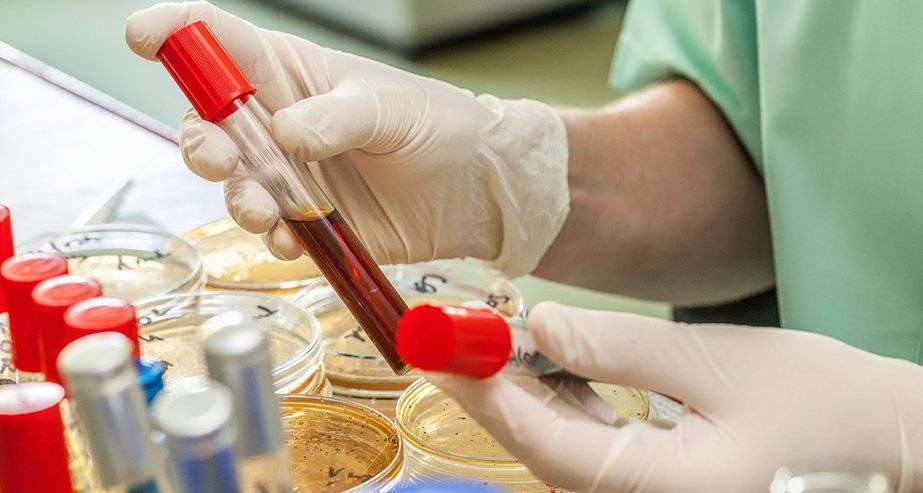

Причины появления в крови

Тяжелая инфекция может привести к появлению миелоцитов
У здорового человека ни миелоцитов, ни других незрелых клеток миелоцитарного ростка кроветворения в анализе крови быть не должно. Даже незначительные концентрации делящихся и созревающих клеток считаются вариантом патологического состояния.
Обнаружение юных форм гранулоцитов свидетельствует о том, что организм подвержен опасности и борется с одним из указанных ниже заболеваний или патологических процессов:
- острые бактериальные и вирусные инфекции, чаще всего осложняющиеся гнойным воспалением. Это могут быть гнойные ангины, прочие тяжелые инфекции ЛОР-органов, острые пиелонефриты, пневмонии, холера, сепсис, скарлатина, туберкулез, брюшной тиф, бруцеллез, паратиф, корь, краснуха паротит и пр.
- состояния после тяжелых инфекционно-воспалительных процессов;
- аппендицит и другая острая хирургическая патология;
- гангрена;
- ожоговая болезнь тяжелых форм;
- инсульты, инфаркты;
- острая кровопотеря любого генеза;
- метастазирование в костный мозг;
- синдром распада опухолей;
- последствия химиотерапевтического, лучевого лечения;
- длительный прием цитостатических, иммуносупрессивных медикаментозных средств;
- отравление свинцом;
- алкоголизм;
- все виды комы;
- ацидоз;
- шок;
- тяжелые и постоянные физические нагрузки;
- многие виды анемий;
- лейкозы;
- миелоидная лейкемия;
- дефицит цианокобаламина и/или фолиевой кислоты.

Бластный криз в мазке крови
Если концентрация бластных клеток в крови повышена незначительно — до 2% к общей лейкоцитарной массе, — то речь идет о хронических лейкозах.
Высокие значения бластов в крови являются признаком выраженных сбоев в деятельности костного мозга, что указывает на острый лейкоз.
Превышение количества бластных клеток в крови более 5% свидетельствует о развитии бластного криза у пациентов с хроническими миелолейкозами, а также о терминальном этапе при онкологической патологии.
Обнаружение миелоцитов, промиелоцитов и метамиелоцитов в крови не более 5% — не говорит и наличии гематологических заболеваний, но все же указывает на наличие определенных трудностей со здоровьем.
А вот значительный подъем от 10% и выше — весьма неблагоприятный показатель, является маркером миелопролиферативных заболеваний — хронических лейкозов, которые берут свое начало от молодых клеток миелоидного ростка кроветворения.
Самая частая причина обнаружения миелоцитов и других созревающих клеток лейкоцитопоэза — хронический миелолейкоз, субстратом которого являются преимущественно незрелые нейтрофильные миелоциты и другие юные формы.
На начальных этапах заболевания рост миелоцитов выражен не ярко. Прогрессирование миелолейкоза сопровождается значительным ростом миелоцитов в крови, а также зрелых эозинофилов и базофилов. Резкий рост незрелых нейтрофилов, т.е., нейтрофильных миелоцитов — крайне неблагоприятный признак, который ухудшает течение лейкоза и прогноз.
Что такое метамиелоциты
 : 1 088
: 1 088
Для установки диагноза любой болезни, необходимо пройти ряд обследований, включая общий анализ крови.
Это важная диагностика, в процессе которой определяется соотношение главных элементов состава крови: лейкоциты, тромбоциты, эритроциты.
Немаловажную роль для оценки состояния здоровья, играет форма белых телец — метамиелоциты в крови. Что это значит в анализе, какие должны быть показатели нормы метамиелоцитов?
Морфология
Метамиелоцит (юный нейтрофил) – это незрелые гранулоциты лейкоцита. Происходит от миелоцита крови, затем превращается в зрелый сегментоядерный гранулоцит.
Морфологически характеризуется почкоообразной формой ядра, отсутствием ядрышек и обильным количеством цитоплазмических гранул.
Метамиелоцит
Норма
Так как лейкоциты формируются в костном мозге, узнать точное количество показателей нормы метамиелоцитов не является возможным. На большую сосредоточенность юных нейтрофиов в общем анализе крови, показывает сдвиг лейкоцитарной формулы влево. Это свидетельствует о наличии воспаления в организме, абсолютном лейкоцитозе, лейкемии крови и прочее.
Для расшифровки анализа крови, для подсчета берется около 200 клеток лейкоцитов. Далее идет подсчет каждой популяции белого кровяного ростка в отдельности, включая определенные структуры. У взрослого и ребенка, референтные показатели лейкоцитограммы отличаются.
Таблица показателей метамиелоцитов в лейкоцитарной формуле
Причины обнаружения
Как уже отмечалось выше, в нормальном анализе крови, метамиелоциты у детей и взрослых не присутствуют. Если их обнаруживают, это говорит о том, что новые клетки не созревают до своего полноценного состояния. Как следствие, организму тяжело самостоятельно побороть инфекционное заболевание. Такое нарушение имеет название – лейкемоидная реакция.
Причины появления метамиелоцитов в плазме крови у ребенка и взрослого могут быть не только болезни:
- Обширный ожог, депрессия, стресс, травмы психологического характера.
- Тяжелая, жирная пища, отравления, аллергические реакции, прием различных медикаментов, также могут спровоцировать нарушения.
- Отдельно стоит отметить физиологический лейкоцитоз крови, который протекает эпизодически с коротким промежутком времени.
- Обнаружить метамиелоциты в анализе крови можно и при таких инфекционных заболеваниях, как: скарлатина, дифтерия, тиф.
Депрессия может спровоцировать наличие метамиелоцитов в анализе крови
Подготовка к анализу
Чтобы получить точные значения в общем анализе крови, пациенту следует правильно подготовиться к исследованию на метамиелоциты.
Определенные правила, которые необходимо соблюдать:
- Кровь сдают натощак, время от последнего приема пищи должно быть не менее 8-10 часов.
- Ужин накануне анализа должен быть постным.
- За 2-3 дня до диагностики, исключить из употребления пищу, богатую животными жирами, копчености, алкогольные напитки. В противном случае, лучше отложить анализ.
- Нельзя посещать сауну, принимать длительно горячу ванну.
- Утром, до забора крови – не курить.
- Физиотерапевтические процедуры, рентген, проводить только после исследования.
Что влияет на результат
Повлиять на расшифровку общего анализа крови могут различные факторы. Их необходимо знать, чтобы исключить ложных результатов:
- Нарушение правил подготовки к диагностике. Забор крови был произведен сразу после приема пищи, проведения рентгена, физиотерапии.
- Возбужденное эмоциональное состояние, физическая нагрузка. Даже незначительный подъем по лестничной площадке может повлиять на результат анализа крови. Поэтому, если присутствуют такие факторы, пациенту лучше немного отдохнуть.
- Прием антибиотиков, гормональных, противовоспалительных, жаропонижающих средств и других лекарственных препаратов.
Лечение
Если обнаружены метамиелоциты в крови у ребенка, новорожденного, врач в обязательном порядке выясняет причину и назначает ряд дополнительных обследований для установления диагноза.
Важным этапом лечения метамиелоцитов является прием витаминных комплексов, коррекция питания, назначение медикаментов. Если причиной метамиелоцитов в организме являются лекарственные средства, которые принимает человек, их отменяют или заменяют другой лекарственной формой. После лечения, сдают повторный анализ (через 2 недели).
Метамиелоциты в крови здорового человека не наблюдаются, их быть не должно. При снижении защитных функций организма, данные лейкоцитные клетки обнаруживаются в анализе, что может говорить о заражении человека бактериальными или различными вида вирусными инфекциями.
Анализы для диагностики заболеваний крови
Для выявления наличия незрелых лейкоцитов в крови, достаточно общего анализа крови, который является обязательным при диагностических обследованиях
Важное значение имеет правильное проведение исследования
Необходимо соблюдать следующие правила:
- анализ проводится утром, натощак;
- необходимо за сутки до обследования исключить из рациона жирную, мясную пищу, алкоголь;
- нельзя проводить исследование после рентгеновского облучения, физиотерапевтических процедур;
- временно отменить прием кортикостероидов, левомицетина, анальгетиков;
- перед процедурой надо избегать психоэмоциональных и физических нагрузок.
Метамиелоциты в крови – повод для биопсии костного мозга. Специальной иглой с ограничителем проводят пункцию грудины. Поршнем шприца создают отрицательное давление, аспирируют некоторое количество костномозгового вещества. Излишнюю кровь удаляют пипеткой. Возможно проведение биопсии тазовой, пяточной, большеберцовой кости. Исследование дает ценную информацию для изучения заболеваний системы кроветворения.
Цитогенетический анализ позволяет выявить нарушения численного состава хромосом клетки. Полимераз – цепная реакция – с большой точностью определяет последовательность полипептидной цепи в молекуле ДНК, выявляет генетические повреждения. Полученные данные позволяют проводить точную диагностику, служат основой для создания новых методов лечения заболеваний.
Причины появления миелоцитов в крови
Если при расшифровке общеклинического анализа крови были обнаружены именно такие клетки, то это является тревожным сигналом, указывающим на протекание:
- широкого спектра бактериальных и вирусных инфекций;
- острой формы пиелонефрита;
- воспалительного процесса в червеобразном отростке;
- некроза, который может быть сформирован на фоне инфаркта или инсульта, гангрены или обширных ожоговых ранений;
- тяжелой интоксикации, например, тяжелыми металлами, химическими веществами или алкоголем;
- онкопатологий, в частности, в тех периодах, когда злокачественное новообразование уже подверглось распаду;
- брюшного тифа;
- бруцеллеза;
- паратифа;
- кори или гриппа;
- краснухи или лейкоза;
- В12-дефицитной анемии;
- лучевой болезни, которая может стать следствием длительного облучения организма, проведением химиотерапии или радиотерапии;
- злокачественных недугов крови;
- апластической формы малокровия.
Не редкостью является появление миелоцитов в случаях передозировки или неадекватного применения лекарственных препаратов, в частности, иммунодепрессантов или обезболивающих веществ.
Миелоциты в крови у ребенка могут возникнуть на фоне:
- врожденных пороков сердца;
- тяжелого отравления организма, например, свинцом или лекарствами, что негативно сказывается на функционировании костного мозга;
- воспалительного поражения легких;
- ангины и ацидоза;
- туберкулеза;
- острых гнойно-воспалительных процессов;
- формирования раковой опухоли;
- интоксикации токсинами, выделяемыми болезнетворными микроорганизмами;
- обширных внутренних кровоизлияний;
- болезней ЖКТ;
- сильнейшего обезвоживания;
- обильной рвоты;
- метастазирования онкологического процесса в костный мозг;
- коматозного или шокового состояния;
- некорректного использования медикаментов;
- различных болезней крови.
Примечательным является то, что у детей наличию миелоцитов в крови может способствовать чрезмерная физическая нагрузка.
Миелоциты в крови при беременности могут выступать в качестве как совершенно нормального явления, так и признака течения одного из вышеуказанных заболеваний. Они также могут означать присутствие обычной простуды или воспаления горла. В то же время они не оказывают никакого влияния на плод.
В норме, в периферической крови у представительницы женского пола во время вынашивания ребенка может присутствовать не больше 3% подобных веществ. Их возникновение обуславливается снижением сопротивляемости иммунной системы, в противном случае закрепление оплодотворенной яйцеклетки могло бы и не состояться.
Общая характеристика миелоцитов
Миелоциты, или, как их еще называют, метамиелоциты – это несформировавшиеся лейкоциты, сконцентрированные в костном мозге. Если человек здоров, незрелые клетки не покидают привычное место обитания. Напротив, миелоциты в общем кровотоке указывают на наличие в организме патологического процесса, нередко инфекционного характера
Важно отметить, что появление незрелых клеток – это сигнал о том, что ресурсы организма практически исчерпаны. Согласно традиционной градации, в первую очередь в роли защитников выступают зрелые гранулоциты, затем палочкоядерные нейтрофилы и только после них приходит очередь миелоцитов, которые все это время «сидели на скамейке запасных»
Отличительные черты миелоцитов – это довольно крупное нейтрофильное ядро округлой формы и зернистость в цитоплазме.
По мере роста и развития незрелые лейкоциты трансформируются в сегментоядерные гранулоциты. Можно с уверенностью констатировать, что миелоциты принимают непосредственное участие в процессе кроветворения.

Методы лечения
Прежде всего, для снижения концентрации миелоцитов в крови необходимо установить причину, спровоцировавшую такое состояние.
Как правило, в большинстве случаев такое происходит на фоне возбудителя инфекции, что может способствовать формированию гнойных образований или воспалительных процессов.

До настоящего времени еще не удалось разработать такое лекарственное средство, которое бы прямым образом смогло устранить появление миелоцитов в плазме. Требуется проведение комплексного мероприятия.
Если течение болезни имеет выраженный характер, врач назначает противовоспалительные препараты с содержанием гормональных компонентов. Чтобы снять сопутствующую симптоматику, могут быть прописаны дополнительные медикаменты.
При сильной интоксикации принимают меры против нее и исключают любой контакт с раздражающим фактором.
Далее используют лекарства, помогающие восстановить питание тканей и иммунитет пациента. В качестве дополнительных средств рекомендуются биологически активные добавки.
Иногда больному бывает достаточно пересмотреть свое питание, включив в рацион продукты, содержащие много витаминов А, С и В.

Запрещены к употреблению консерванты, копченые изделия, жирные блюда.
Сбалансированное питание способствует укреплению иммунной системы, которая будет в состоянии побороть патогенные микроорганизмы.
Миелоциты являются важными компонентами организма человека, которые локализуются в костном мозге. В нормальном состоянии их присутствие в составе крови не должно быть обнаружено.
Наличие незрелых клеток в ней свидетельствует о развитии какого-либо заболевания. Только при своевременном проведении терапевтических мероприятий удастся нормализовать миелоидные показатели и состояние больного.
Что такое миелоциты и их виды
Предшественником абсолютно любой клетки крови считается особая стволовая клетка. Она обладает двумя важными особенностями:
- Способна превратиться в любую другую цитологическую структуру. То есть дифференцироваться.
- Не погибает после некоторого числа делений. Как это случается с обыкновенной, функционально определенной клеткой.
В специальных структурах, известных как отростки костного мозга, происходит дифференциация цитологических единиц. Миелоциты в крови — это особые промежуточные клетки, уже не стволовые, но еще и не функционально активные. В норме в анализе их быть не должно.
Допустимы некоторые исключения. Например, при приеме препаратов, угнетающих гемопоэз. Но это скорее редкие возможные случаи, а не закономерные изменения и процессы.
На первой стадии стволовые клетки дифференцируются на два вида:
- Материнские миелопоэтические. Из них образуются собственно сами гранулоциты, но не сразу. То есть клетки, которые в основном отвечают за иммунный ответ. Также из этих структур появляются эритро — и тромбоциты.
- Материнские лимфопоэтические. Как и следует из названия, в результате дальнейшего созревания образуются лимфоциты — агранулоцитарные разновидности иммунных клеток.

На второй стадии из миелопоэтической клетки появляется три новых вида более зрелых вариантов:
- Эритробласт. Из него формируются эритроциты.
- Мегакариобласт. Предшественник тромбоцитов.
- Миелобласт. Из него образуются все гранулоциты.

На третьем этапе из миелобласта появляется промиелоциты и затем миелоциты, о которых идет речь. Если рассматривать схему более подробно, то миелоцитов существует три типа: нейтрофильные, базофильные и эозинофильные.

На следующей стадии, миелоциты делятся на метамиелоциты это предшественники гранулоцитов, особых клеток иммунной системы человека, которые участвуют в работе защитных сил тела.

Как только заканчивается эта стадия, начинается финальная. Из предшественниц цитологических структур образуется 3 вида лейкоцитов — клеток миелоидного ряда.

Базофилы
Наиболее крупные белые клетки крови. Намного больше прочих из названной группы. Обладает способностью инактивировать бактерии и вирусы. Это происходит благодаря особому строению клетки.
- С одной стороны, она способна к фагоцитозу. То есть поглощению инородного объекта.
- С другой — выделяет гистамин и прочие токсические вещества в окружающую среду для уничтожения инородных агентов.
- С третьей — несет на себе особые иммуноглобулины, которые подавляют развитие бактерий и вирусов.
Базофилы играют основную роль в аллергических реакциях. В крови всего около 1% от общей массы гранулоцитов.
Эозинофилы
Имеют округлую форму и сдвоенное ядро в виде перемычки. Как и названные выше клетки, обладает способностью к фагоцитозу. Однако основная функция эозинофила — противопаразитарная.
Благодаря особому строению наружной мембраны, цитологическая структура прилипает к личинкам гельминтов и растворяет их. Это главная задача, однако не единственная.
Как и базофилы, клетки способны бороться с вирусами и бактериями. Созревают они порядка 12 часов, после чего выходят в кровеносное русло. Это отличает их от предыдущих структур, которым нужно почти двое суток на «подготовку».
Эозинофилия также часто указывает на аллергию. Количество цитологических структур этого типа — почти 5%.
Нейтрофилы
Наиболее многочисленные. Составляют по разным оценкам, до 80% от общей массы гранулоцитов. Есть и другие выкладки. По всей видимости, разночтения связаны с динамикой процесса кроветворения, созревания клеток. Вариантов несколько.
Сами по себе нейтрофилы неоднородны. В кровеносном русле обнаруживаются их модификации. В том числе незрелые. Либо же сегментоядерные, палочкоядерные.

Они выполняют разные функции, но оба поглощают и переваривают чужеродные структуры. Это так называемый микрофагоцитоз.

Примерная продолжительность жизни нейтрофилов составляет 12 дней. Плюс-минус.
Подробнее о нормах и причинах отклонений концентрации нейтрофилов в крови читайте здесь.
Причины повышения у детей
Как уже упоминалось выше, юные формы белых телец у новорожденных младенцев могут достигать 4%, и такой показатель будет расцениваться как нормальный. Но при этом к концу второго месяца жизни малышей коэффициент должен упасть до 0% и оставаться неизменным на протяжении всего существования человека.
 Основные лабораторные признаки хронического миелолейкоза
Основные лабораторные признаки хронического миелолейкоза
В любом случае, если в результатах анализа были обнаружены повышенные миелоциты, обязательно следует пройти полное обследование. Это поможет исключить либо выявить наличие у ребенка патологических отклонений функционирования кроветворной системы
Очень важно не пропустить у малыша развития серьезных заболеваний
Чаще всего сдвиг лейкоцитарной формулы в детском возрасте вызывают следующие нарушения:
- ожоговые поражения больших участков тела;
- аллергические реакции, аутоиммунные заболевания;
- побочные эффекты от приема медпрепаратов;
- тяжелые психологические переживания, стрессы;
- отравление пищевыми продуктами или тяжелыми металлами;
- интоксикация на фоне тяжелой инфекционной болезни.
При лейкемоидной реакции, то есть обратимого изменения состояния белой крови, детская иммунная система не способна справляться в полной мере с возложенными на нее обязанностями, поскольку у ребенка в этом возрасте еще недостаточно зрелых лейкоцитов.
Но иногда наличие в исследуемом биоматериале до 1% метамиелоцитов без изменения количества других форменных элементов расценивается как физиологическое повышение. Для решения проблемы повышения описываемых клеток специалисты первым делом ставят задачу выяснить причины возникновения отклонений в анализах у детей, после чего разрабатывают соответствующую терапевтическую тактику.
При легких инфекционных болезнях назначаются витаминные комплексы, корректируется рацион и режим питания, а также при необходимости прописываются препараты, направленные на уничтожение возбудителя. После двухнедельного курса терапии выполняется повторная диагностика.
Если показатели лейкоцитарной формулы восстанавливаются до нормальных, то это означает, что лечение подобрано правильно. В случае когда значения метамиелоцитов остаются неизменными, то есть завышенными, врачи пересматривают назначения и выбирают альтернативные лекарственные препараты.
Повышенные показатели: что это значит?
Пациентам не всегда понятно, почему в общем анализе такое большое количество различных видов состава крови. Они задают вопросы: «Зачем подсчитывать непонятные нейтрофилы или метамиелоциты? Вроде бы нужно знать только общий уровень основных клеток – эритроцитов, лейкоцитов и тромбоцитов».
На самом деле, общий анализ содержит всю необходимую информацию о состоянии здоровья пациента. Врачи никогда не смотрят на какой-то один показатель, чтобы выявить нарушения в организме
Всегда берется во внимание комплексное значение величин, их сдвиги и соотношение друг к другу
Поэтому, чтобы понять, почему важно рассматривать количество миелоидных форм, следует разобраться с функциональностью нейтрофилов, их зрелых клеток
- Нейтрофильные миелоциты – это младенцы, которые совсем беспомощные и безопасные. Они ждут взросления.
- Нейтрофильные метамиелоциты – юные тельца, не способные защищать организм, пока не дорастут до следующей стадии.
- Палочкоядерные нейтрофилы – неопытные защитники, но уже справляются со своими функциями, хоть и не так быстро.
- Сегментоядерные нейтрофилы – зрелые тельца, полностью вооруженные и готовые выполнять задачи иммунной системы.
Как раз последние два вида лейкоцитных клеток уже должны обнаруживаться в крови, потому что способны защищать человека от нападения болезнетворных микроорганизмов и чужеродных агентов. В норме сегментоядерных телец насчитывается 50-70%, а палочкоядерных всего 1-6%.
Зернистость цитоплазмы также очень важна, потому что в гранулах содержаться все необходимые вещества для уничтожения вредителей. Как только в организме возникает воспаление, лейкоциты быстро атакуют врага и выводят токсины.
Но если вдруг иммунитет не справляется с заболеванием, то на помощь из костного мозга начинают выделяться еще незрелые клетки – миелоциты и метамиелоциты. Повышенные цифры должны насторожить пациента. Несмотря на их беспомощность в функциональном плане, по анализу можно понять, что борьба отчаянная и необходимо срочно атаковать чужеродного агента медикаментами.
Миелоцит
Размер миелоцита — 8 — 18 мкм. В миелоцитах различают две генерации — крупные незрелые материнские миелоциты и меньших размеров зрелые дочерние миелоциты. Дочерние миелоциты образуются из материнских в результате пролиферации и дифференциации. Ядра миелоцитов сочные , с характерным чередованием более светлых и более темных участков хроматина. Рисунок хроматина в ядре зависит от степени зрелости клеток: более мелкий, сглаженный, рыхлый — у незрелых миелоцитов и более крупный, грубый и густой — у зрелых. Материнскому миелоциту свойственно ядро рыхлой структуры, как бы набухшее, а дочернему — овальное, бобовидное или бухтообразное, глыбчатое. Ядрышки в ядре миелоцита, как правило, отсутствуют.
Цитоплазма нейтрофильного миелоцита окрашивается в светлый сине- или фиолетово-коричневый тон у материнских форм и розоватый — у дочерних. В центре клетки, вблизи ядра, в области расположения комплекса Гольджи окраска цитоплазмы менее интенсивна. По наличию этого просветления в цитоплазме миелоциты можно легко дифференцировать даже в тех случаях, когда зернистость плохо окрашена или совсем не окрашена (при лейкозах). Зернистость мелкая, такого же типа, как и у зрелых нейтрофильных гранулоцитов, но среди мелких гранул всегда располагаются и более крупные.
Цитоплазма эозинофильного миелоцита окрашивается в голубой цвет, густо «нафарширована» эозинофильной (ярко-оранжевой) зернистостью, среди которой могут встречаться гранулы синего или фиолетово-красного цвета (более молодая эозинофильная зернистость).
Цитоплазма базофильного миелоцита также окрашивается в голубой цвет. Зернистость отличается колебаниями в оттенках окраски отдельных гранул (темно-синяя, синяя, фиолетово-красная), форме и количестве гранул.
В нормальных условиях только дочерние миелоциты через метамиелоциты переходят в полиморфные лейкоциты. Материнские миелоциты, не давшие дочерних генераций, могут в дальнейшем развиваться в зрелые полиморфные лейкоциты только в патологических условиях. Такие лейкоциты имеют большую величину и большее количество сегментов в ядре. Кроме этого при патологических процессах, особенно при лейкозах, в миелоцитах отмечается несоответствие в развитии ядра и цитоплазмы, а также зернистости клеток.
Отклонение от нормы MID
Если концентрация MID в анализе крови повышена или понижена, то это обычно говорит о патологии. На этот показатель не влияют случайные причины, и результаты обследования редко бывают искажены. Но ставить диагноз только по сокращенному ОАК невозможно. Поэтому в таких случаях назначают исследование на лейкоцитарную формулу.

Если MID в анализе крови повышен, что это значит? Такие показатели свидетельствуют о том, что организму приходится бороться с патологией. И по этой причине лейкоцитарные клетки вырабатываются в большом количестве. Чтобы предположить характер заболевания, необходимо сделать более подробный анализ.
Чаще встречаются патологии, при которых MID в анализе крови повышен. Низкий уровень этого показателя наблюдается реже. Это может быть при нарушениях кроветворения, приеме некоторых лекарств, интоксикации, анемии, снижении иммунитета. В этих случаях тоже назначают дополнительное развернутое исследование на эозинофилы, базофилы и моноциты.
Миелоциты
Миелоциты (син. миелобласты, промиелоциты, метамиелоциты) – являются компонентами, вырабатываемыми в костном мозге, которые относятся к категории лейкоцитов и предполагают наличие ядра, называющегося нейтрофилом. У здорового взрослого человека или ребенка такие вещества во время расшифровки анализов крови должны полностью отсутствовать.
Появлению таких веществ в периферическом кровотоке способствуют в основном различные патологические процессы и заболевания. Например, вирусные патологии и инфицирование кишечника, злокачественные образования и протекание некроза, внутренние кровоизлияния и болезни крови. Помимо этого, в качестве причины может выступать передозировка лекарственными препаратами.
Специфические клинические проявления, указывающие на присутствие миелоцитов в крови, отсутствуют. Симптоматическая картина будет состоять лишь из симптомов провоцирующего недуга.
Обнаруживаются такие вещества только в анализе крови, расшифровкой которого занимается врач-гематолог. Для выяснения причинного фактора необходимо комплексное лабораторно-инструментальное обследование.
В случае обнаружения миелоцитов в крови человека, прежде всего, необходимо заняться лечением основной болезни. Это объясняется тем, что в настоящее время не существует специальных препаратов, позволяющих вывести такие компоненты из главной биологической жидкости.
Подготовка к анализу
Чтобы получить точные значения в общем анализе крови, пациенту следует правильно подготовиться к исследованию на метамиелоциты.
Определенные правила, которые необходимо соблюдать:
- Кровь сдают натощак, время от последнего приема пищи должно быть не менее 8-10 часов.
- Ужин накануне анализа должен быть постным.
- За 2-3 дня до диагностики, исключить из употребления пищу, богатую животными жирами, копчености, алкогольные напитки. В противном случае, лучше отложить анализ.
- Нельзя посещать сауну, принимать длительно горячу ванну.
- Утром, до забора крови – не курить.
- Физиотерапевтические процедуры, рентген, проводить только после исследования.
Миелоциты в крови: причины, диагностика и лечение
 Промиелоциты, миелоциты, метамиелоциты в крови должны отсутствовать у здорового человека. Их появление имеет ряд патологических причин. Могут возникать на фоне воспалительных процессов в организме — пневмония, туберкулез, пиелонефрит, инфекционные болезни ЛОР-органов. Ожоги и другие травмы, сопровождающиеся потерей крови и некрозом тканей, вызывают образование клеток данного типа в крови.
Промиелоциты, миелоциты, метамиелоциты в крови должны отсутствовать у здорового человека. Их появление имеет ряд патологических причин. Могут возникать на фоне воспалительных процессов в организме — пневмония, туберкулез, пиелонефрит, инфекционные болезни ЛОР-органов. Ожоги и другие травмы, сопровождающиеся потерей крови и некрозом тканей, вызывают образование клеток данного типа в крови.
Выявление в анализе миелоцитов может сигнализировать о лейкозе и других онкологических заболеваниях. Возникает при ацидозе, после перенесенного инсульта и инфаркта, в состоянии комы и шока, при проведении лучевой и химиотерапии. Отклонение может быть обозначением отравления организма, дефицита железа и фолиевой кислоты, физической перегрузки. Прием некоторых медикаментов вызывает появление в крови данных клеток.
 Миелоциты в крови у ребенка могут иметь другие причины, чем у взрослого. Возникают на фоне заболеваний желудочно-кишечного тракта, врожденного порока сердца, обезвоживании и интоксикации организма, ослаблении иммунитета, а также при повышенных физических нагрузках. Для новорожденных нормальным является показатель 0.5%. У беременных женщин незначительное повышение в крови миелоцитов допустимо. Предельное содержание — 3%.
Миелоциты в крови у ребенка могут иметь другие причины, чем у взрослого. Возникают на фоне заболеваний желудочно-кишечного тракта, врожденного порока сердца, обезвоживании и интоксикации организма, ослаблении иммунитета, а также при повышенных физических нагрузках. Для новорожденных нормальным является показатель 0.5%. У беременных женщин незначительное повышение в крови миелоцитов допустимо. Предельное содержание — 3%.
Диагностика
К анализу крови на выявление содержания клеток потребуется специальная подготовка. Забор материала должен осуществляться натощак. Запрещено употребление алкоголя накануне исследования, жирной, жареной и соленой пищи, а также курение непосредственно перед анализом. Рентген или физиопроцедуры могут исказить результат. Для точности потребуется несколько анализов.
После лабораторного исследования необходима консультация терапевта. На основании данных, полученных в результате осмотра, а также после изучения анамнеза пациента, назначаются дополнительные диагностические меры. Лечение зависит от причины отклонения и возможно только после ее выявления.
После лабораторного исследования необходима консультация терапевта. На основании данных, полученных в результате осмотра, а также после изучения анамнеза пациента, назначаются дополнительные диагностические меры. Лечение зависит от причины отклонения и возможно только после ее выявления.
Важно!
Превышение миелоцитов на 10% и более угрожает жизни человека. Требуется немедленная госпитализация.
Лечение и профилактика
 Появление миелоцитов в крови не является самостоятельным заболеванием, поэтому тип лечения определяется причиной их появления в крови. Возможна медикаментозная терапия, хирургическое вмешательство, либо их комплекс. Отклонение, вызванное дефицитом железа или фолиевой кислоты, устраняется коррекцией рациона и употреблением специальных препаратов. При возникновении патологии на фоне приема некоторых медикаментов, необходима полная их отмена или замена аналогичными по действию препаратами. Правильно подобранная терапия приводит в норму показатели за 2-3 недели.
Появление миелоцитов в крови не является самостоятельным заболеванием, поэтому тип лечения определяется причиной их появления в крови. Возможна медикаментозная терапия, хирургическое вмешательство, либо их комплекс. Отклонение, вызванное дефицитом железа или фолиевой кислоты, устраняется коррекцией рациона и употреблением специальных препаратов. При возникновении патологии на фоне приема некоторых медикаментов, необходима полная их отмена или замена аналогичными по действию препаратами. Правильно подобранная терапия приводит в норму показатели за 2-3 недели.
 Профилактическими мерами являются здоровый образ жизни, сбалансированное питание, умеренные физические нагрузки. Не следует заниматься самолечением и бесконтрольно принимать лекарственные препараты. Необходимо исключить воздействие токсических и радиоактивных веществ.
Профилактическими мерами являются здоровый образ жизни, сбалансированное питание, умеренные физические нагрузки. Не следует заниматься самолечением и бесконтрольно принимать лекарственные препараты. Необходимо исключить воздействие токсических и радиоактивных веществ.
Миелоциты обеспечивают полноценное созревание важных клеток в организме человека — гранулоцитов. Они необходимы для функционирования иммунитета человека и процесса кроветворения. В норме миелоциты должны содержаться только в костном мозге в виде эозинофильных, базофильных и нейтрофильных клеток. Появление этих составляющих в крови сигнализирует о гематологических отклонениях или развитии опасных патологий. Для назначения лечения необходимо выявление причины данного отклонения.
‘;document.body.appendChild(d);document.pnctLoadStarted=(new%20Date()).getTime();document.pnctCnclLoad=function(){document.pnctLoadStarted=0;pl=document.getElementById(‘pnctPreloader’);if(pl)pl.parentNode.removeChild(pl)};document.getElementById(‘pnctCancelBtn’).addEventListener(‘click’,function(e){e.preventDefault();document.pnctCnclLoad()});setTimeout(function(){var%20st=document.pnctLoadStarted;if(st>0&&((new%20Date()).getTime()-st>=14000)){document.pnctCnclLoad();alert(‘%3C%3F%3DYii%3A%3At%28%22uniprogy%22%2C+%22Unfortunately%2C+the+image+search+is+not+available.%22%29%3F%3E’)}},15000);var%20e=document.createElement(‘script’);e.setAttribute(‘type’,’text/javascript’);e.setAttribute(‘charset’,’UTF-8′);e.setAttribute(‘src’,’//postila.ru/post.js?ver=1&m=b&rnd=’+Math.random()*99999999);document.body.appendChild(e)})());”>
Почему у беременных миелоциты повышены?
Рост концентрации незрелых клеток костного мозга в крови во время беременности обусловлен естественными физиологическими факторами. Нередко организм женщины воспринимает оплодотворенную яйцеклетку как чужеродный объект, от которого следует избавиться как можно скорее. Чтобы снизить активность враждебно настроенных лейкоцитов, иммунная система «сбавляет обороты» и в этом случае вероятность закрепления плодного яйца в матке значительно увеличивается. Однако параллельно в кровоток проникают миелоциты, готовые заменить нейтрализованные лейкоциты. Главное, что требуется от вас и прежде всего от лечащего врача в этот период – следить, чтобы показатели крови оставались в рамках «беременной» нормы.
Кроме этого, меняется и состав крови. Так, при беременности активно формируются гранулоциты, в результате чего небольшой процент миелоцитов способен просочиться в так называемую периферическую кровь.
Квалифицированный врач обязательно повторит анализ, чтобы проследить динамику показателей крови. Если будет прослеживаться тенденция к повышению незрелых клеток, то женщине потребуется пройти соответствующее обследование, чтобы исключить патогенные заболевания.

Патологические причины роста миелоцитов
Мы выяснили, что миелоциты в крови могут повышаться как в силу физиологических причин, так и ввиду патологических состояний
Во время гестации критически важно отличить одно от другого путем своевременной правильной диагностики
Рассмотрим основные причины повышения миелоцитов:
- острые инфекции, спровоцированные различного рода бактериями;
- тиф, паратиф;
- интоксикации организма;
- некроз, отмирание клеток;
- период распада злокачественных образований, метастазы головного мозга;
- обильные кровопотери;
- противоопухолевая терапия;
- инфекции вирусной этиологии;
- употребление конкретного спектра препаратов;
- сильные отравления;
- коматоз;
- кислотно-щелочной дисбаланс – ацидоз;
- заболевания крови;
- недавние инфекции в анамнезе;
- чрезмерные физические нагрузки.


















































